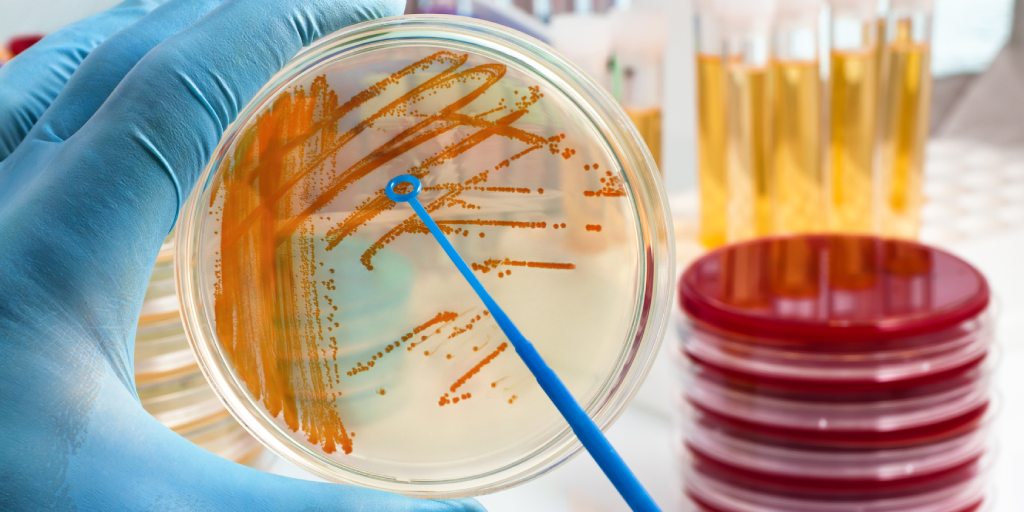
gronkowiec

Gronkowiec złocisty – czym jest i jak sobie z nim radzić?
- Gronkowce – podział
- Gronkowce w organizmie człowieka – nosicielstwo a zakażenie
- Jak można zarazić się gronkowcem?
- Zakażenia gronkowcowe ran, układu moczowego i jelit – diagnostyka i objawy
- Diagnostyka nosicielstwa Staphylococcus aureus – jakie badania wykonać?
- Leczenie zakażeń gronkowcowych
- Pytania i odpowiedzi
Gronkowce (Staphylococcus) to Gram-dodatnie bakterie należące do grupy ziarniaków, które kolonizują skórę i błony śluzowe człowieka oraz zwierząt. Są wszechobecne w środowisku – występują w powietrzu, wodzie, glebie, a także na przedmiotach codziennego użytku. Większość gatunków to niegroźne komensale, które w normalnych warunkach nie wywołują chorób.
Obecnie znane są 32 gatunki gronkowców, z których 16 powoduje zakażenia u ludzi. Do najczęściej spotykanych należą Staphylococcus epidermidis, Staphylococcus saprophyticus, Staphylococcus lugdunensis, Staphylococcus haemolyticus oraz Staphylococcus aureus, czyli gronkowiec złocisty.
Gronkowce – podział
Gronkowce dzielimy na 2 grupy, ze względu na zdolność wytwarzania enzymu jakim jest koagulaza. Wśród nich wyróżniamy:
- Gronkowce koagulazododatnie (np. S. aureus), które wytwarzają enzym koagulazę i są najbardziej patogenne.
- Gronkowce koagulazoujemne (np. S. epidermidis, S. saprophyticus), które zwykle są niegroźne, ale u osób z obniżoną odpornością mogą prowadzić do zakażeń oportunistycznych.
Gronkowce w organizmie człowieka – nosicielstwo a zakażenie
Gronkowce stanowią element naturalnej flory bakteryjnej człowieka, kolonizując przede wszystkim skórę, błony śluzowe nosa, gardła i przewodu pokarmowego. Staphylococcus epidermidis oraz inne gronkowce koagulazoujemne są powszechne na powierzchni skóry, pełniąc rolę komensali, które konkurują z bardziej patogennymi drobnoustrojami. Z kolei Staphylococcus aureus bytuje u około 30% populacji w przednich odcinkach nosa (bezobjawowe nosicielstwo), a u części osób również w gardle, okolicach pachwin i na skórze. W normalnych warunkach układ odpornościowy skutecznie kontroluje te bakterie, zapobiegając infekcjom.
Do rozwoju zakażenia dochodzi najczęściej w sytuacjach, gdy naturalna bariera skórno-śluzówkowa zostaje przerwana lub gdy dochodzi do zaburzenia równowagi immunologicznej. Czynniki sprzyjające infekcjom gronkowcowym to:
- uszkodzenia skóry (rany, oparzenia, zabiegi chirurgiczne, wkłucia dożylne),
- przewlekłe choroby (cukrzyca, nowotwory, HIV),
- terapia immunosupresyjna (np. po przeszczepach),
- długotrwała antybiotykoterapia, która niszczy konkurencyjną florę bakteryjną,
- obecność ciał obcych (sztuczne zastawki, cewniki, endoprotezy), stanowiących idealne miejsce dla tworzenia biofilmu bakteryjnego.
W takich okolicznościach nawet zwykle niegroźne gronkowce koagulazoujemne mogą wywołać zakażenia oportunistyczne, natomiast S. aureus często prowadzi do ropnych infekcji skóry, zapaleń płuc, zakażeń kości i stawów, a nawet sepsy.
Jak można zarazić się gronkowcem?
Gronkowce przenoszą się przez:
- bezpośredni kontakt z osobą zakażoną lub nosicielem,
- kontakt z przedmiotami (np. ręczniki, przybory kosmetyczne, sprzęt na siłowni),
- drogą kropelkową (w przypadku infekcji dróg oddechowych),
- zabiegi inwazyjne (operacje, tatuaże, zabiegi kosmetyczne), jeśli nie są zachowane zasady aseptyki.
Zakażenia gronkowcowe ran, układu moczowego i jelit – diagnostyka i objawy
Gronkowce mogą wywoływać zakażenia w różnych lokalizacjach, w zależności od gatunku i stanu zdrowia pacjenta. Podejmując próbę diagnozy infekcji gronkowcowej należy pamiętać, że morfologia krwi nie wykrywa gronkowca, ale w ciężkich infekcjach może pojawić się leukocytoza (podwyższony poziom białych krwinek). Kluczowe wówczas staje się oddanie materiału do badań mikrobiologicznych.
Zakażenia wywołane przez gronkowce mogą manifestować się w różnorodny sposób, w zależności od lokalizacji infekcji. W przypadku skóry i tkanek miękkich obserwujemy najczęściej czyraki i ropnie (bolesne, wypełnione ropą guzki z czerwoną zapalną otoczką), liszajec zakaźny (charakterystyczne miodowo-żółte strupy głównie u dzieci) oraz zapalenie mieszków włosowych. U niemowląt może wystąpić zespół oparzonej skóry (SSSS) z rozległymi pęcherzami. W układzie oddechowym gronkowce powodują zapalenia zatok, gardła i rzadziej płuc z ropną plwociną. W układzie pokarmowym enterotoksyny gronkowcowe wywołują gwałtowne zatrucia pokarmowe. Najgroźniejsze są zakażenia ogólnoustrojowe – posocznica z wysoką gorączką i zaburzeniami świadomości oraz zapalenie wsierdzia.
W przypadku ran i zmian skórnych wykonuje się posiew z wymazu z miejsca objętego zakażeniem. Poszukiwanym czynnikiem etiologicznym jest Staphylococcus aureus, który dzięki zdolności wytwarzania enzymów i toksyn (np. koagulazy, hemolizyn) łatwo powoduje ropne zapalenia tkanki podskórnej, czyraki, ropnie lub zakażenia pooperacyjne. Gronkowce koagulazoujemne, takie jak S. epidermidis, zwykle kolonizują zakażenia związane z ciałami obcymi (sztuczne zastawki, cewniki naczyniowe), tworząc trudny do eradykacji biofilm. W układzie moczowym S. saprophyticus jest częstym patogenem u młodych kobiet, wywołując zapalenie pęcherza z objawami dyzurycznymi, natomiast S. aureus pojawia się zwykle w przypadku bakteriemii i wstępującego zakażenia nerek. W obydwu przypadkach należy wykonać posiew bakteriologiczny moczu. W jelitach S. aureus może namnażać się po antybiotykoterapii, prowadząc do zatruć pokarmowych (nudności, wymioty, biegunka), ale tylko gdy dany szczep ma zdolność produkcji enterotoksyn. W zatruciach pochodzenia spożywczego należy wykrywać toksyny gronkowcowe przede wszystkim w spożytym pokarmie.
Diagnostyka nosicielstwa Staphylococcus aureus – jakie badania wykonać?
Aby potwierdzić nosicielstwo Staphylococcus aureus (np. w jamie nosowej, gardle lub na skórze), wykonuje się mikrobiologiczny posiew wymazu z miejsc, gdzie bakteria najczęściej bytuje. Standardowo pobiera się wymaz:
- z przedsionka nosa (u większości nosicieli kolonizuje on przednie nozdrza),
- z gardła (zwłaszcza u osób z nawracającymi infekcjami górnych dróg oddechowych),
- z pachwin lub okolic odbytu (rzadziej, ale może być istotne u pacjentów przed zabiegami chirurgicznymi).
Metoda badania:
- Wymazówkę z podłożem transportowym (np. Amies) wprowadza się do nosa/gardła i pobiera próbkę.
- Materiał wysyła się do laboratorium mikrobiologicznego, gdzie wykonuje się hodowlę na podłożach selektywnych.
- Po 24–48 godzinach ocenia się wzrost charakterystycznych kolonii (żółte, hemolizujące).
- W razie potrzeby (np. u pracowników służby zdrowia) można dodatkowo zbadać wrażliwość na metycylinę (MRSA) metodą PCR lub antybiogramem.
Kiedy warto zbadać nosicielstwo?
- Przed planowanymi operacjami (zwłaszcza ortopedycznymi i kardiochirurgicznymi),
- U osób z nawracającymi zakażeniami skóry (czyraki, ropnie),
- U pracowników medycznych i gastronomicznych (ze względu na ryzyko transmisji),
- W przypadku epidemii MRSA w szpitalu lub domu opieki.
Leczenie nosicielstwa (jeśli konieczne) polega na stosowaniu mupirocyny w maści do nosa lub antyseptyków (chlorheksydyna), ale decyzję zawsze podejmuje lekarz.
Leczenie zakażeń gronkowcowych
Terapia zakażeń gronkowcowych wymaga zindywidualizowanego podejścia, uzależnionego od lokalizacji infekcji, stanu pacjenta oraz wrażliwości danego szczepu na antybiotyki. W leczeniu farmakologicznym standardowo stosuje się penicyliny półsyntetyczne (takie jak kloksacylina) lub cefalosporyny I generacji. W przypadku zakażeń wywołanych przez oporne szczepy MRSA konieczne staje się wdrożenie specjalistycznych antybiotyków, do których należą wankomycyna, linezolid czy daptomycyna. W lżejszych, miejscowych zakażeniach skóry skuteczne bywa leczenie miejscowe z zastosowaniem maści z mupirocyną (szczególnie w okolicy nosa) lub innych antybiotyków, jak neomycyna.
Nieodzownym elementem leczenia ropnych zakażeń gronkowcowych jest interwencja chirurgiczna. Drenaż dużych zbiorników ropnych jest absolutnie konieczny, gdyż znacząco poprawia skuteczność prowadzonej równolegle antybiotykoterapii i przyspiesza proces gojenia. Decyzja o wyborze strategii leczenia zawsze należy do lekarza, na podstawie wyników badań mikrobiologicznych i oceny klinicznej stanu pacjenta.
Należy pamiętać, że gronkowce będąc powszechnym elementem naszej mikroflory są wszechobecne, ale nie zawsze są groźne. Stanowią doskonały przykład na to, jak względna jest granica między komensalem a patogenem. Podczas gdy Staphylococcus aureus pozostaje głównym, silnie chorobotwórczym patogenem zdolnym do wywołania ciężkich infekcji ogólnoustrojowych, gatunki koagulazoujemne, takie jak S. epidermidis, pełnią zwykle rolę oportunistów, atakujących osoby z obniżoną odpornością.
Kluczowym wyzwaniem współczesnej medycyny w walce z tymi bakteriami pozostaje ich niepokojąca zdolność do rozwoju oporności na antybiotyki, czego symbolem jest globalne rozprzestrzenienie się szczepów MRSA. To zjawisko w praktyce klinicznej oznacza konieczność ścisłego przestrzegania zasad antybiotykoterapii oraz nieustannego monitorowania wrażliwości szczepów. Nie mniej ważna jest konsekwentna profilaktyka, oparta na podstawowych zasadach higieny.
W przypadku nawracających lub przewlekłych zakażeń bezwzględnie konieczna jest konsultacja z lekarzem i wykonanie specjalistycznych badań mikrobiologicznych, w tym posiewu z antybiogramem. Tylko podejście łączące racjonalną terapię, skuteczną profilaktykę i nowoczesną diagnostykę pozwala na efektywną kontrolę zakażeń gronkowcowych i zapobieganie ich groźnym powikłaniom.
Pytania i odpowiedzi
1. Czy nosicielstwo gronkowca złocistego bez objawów wymaga leczenia?
Nosicielstwo S. aureus nie zawsze wymaga interwencji. Leczenie zaleca się i wdraża w szczególnych sytuacjach:
- Przed planowanymi zabiegami chirurgicznymi
- U osób z nawracającymi infekcjami skóry
- U pracowników służby zdrowia
- W przypadku epidemii MRSA w placówkach medycznych
2. Dlaczego gronkowiec bywa oporny na antybiotyki?
Gronkowce (zwłaszcza S. aureus) szybko uodparniają się na antybiotyki. Ich oporność może wynikać z:
- Produkcji beta-laktamaz – enzymów rozkładających penicyliny
- Modyfikacji białek wiążących penicylinę (PBP2a w MRSA)
- Mutacji genetycznych prowadzących do oporności
W praktyce oznacza to, że zwykłe antybiotyki pierwszego rzutu (np. penicylina) mogą nie działać, a leczenie wymaga silniejszych, bardziej specjalistycznych leków (np. wankomycyny). Dzieje się tak na skutek nadużywania antybiotyków lub poprzez stosowanie nietrafionej antybiotykoterapii nie popartej wynikiem posiewu mikrobiologicznego.
3. Czy można zarazić się gronkowcem na siłowni lub w salonie kosmetycznym?
Tak, ryzyko zakażenia istnieje w miejscach publicznych poprzez:
- bezpośredni kontakt (np. przez nieumyte ręce),
- wspólny sprzęt (ławki, maszyny na siłowni),
- zabiegi kosmetyczne (depilacja, manicure), jeśli narzędzia są źle dezynfekowane/wysterylizowane.
4. Jakie choroby skóry mogą być zaostrzone przez obecność gronkowca?
Gronkowce mogą nasilać przebieg wielu dermatoz:
- Trądzik – gronkowiec może nasilać stany zapalne,
- Atopowe zapalenie skóry (AZS) – bakterie łatwiej wnikają przez uszkodzony naskórek i zaostrzają wyprysk,
- Przewlekłe owrzodzenia (szczególnie u diabetyków) – gronkowiec utrudnia gojenie, często prowadząc do zakażeń głębokich,
- Zapalenie mieszków włosowych,
- Zapalenie tkanki podskórnej.
Bibliografia
Heczko, P. B., Pietrzyk, A., & Wróblewska, M. (red.). (2020). Mikrobiologia lekarska. Wydawnictwo Lekarskie PZWL.
Murray, P. R., Rosenthal, K. S., & Pfaller, M. A. (2020). Medical Microbiology (9th ed.). Elsevier.
Krzyżanowska, A., & Malinowski, A. (2021). Zakażenia szpitalne: zapobieganie i kontrola. Wydawnictwo Naukowe Uniwersytetu Medycznego im. Karola Marcinkowskiego w Poznaniu.
Szewczyk, E. M. (2018). Diagnostyka bakteriologiczna. Wydawnictwo Naukowe PWN.
Tong, S. Y. C., Davis, J. S., Eichenberger, E., Holland, T. L., & Fowler, V. G. (2015). Staphylococcus aureus infections: epidemiology, pathophysiology, clinical manifestations, and management. Clinical Microbiology Reviews, 28(3), 603–661.
